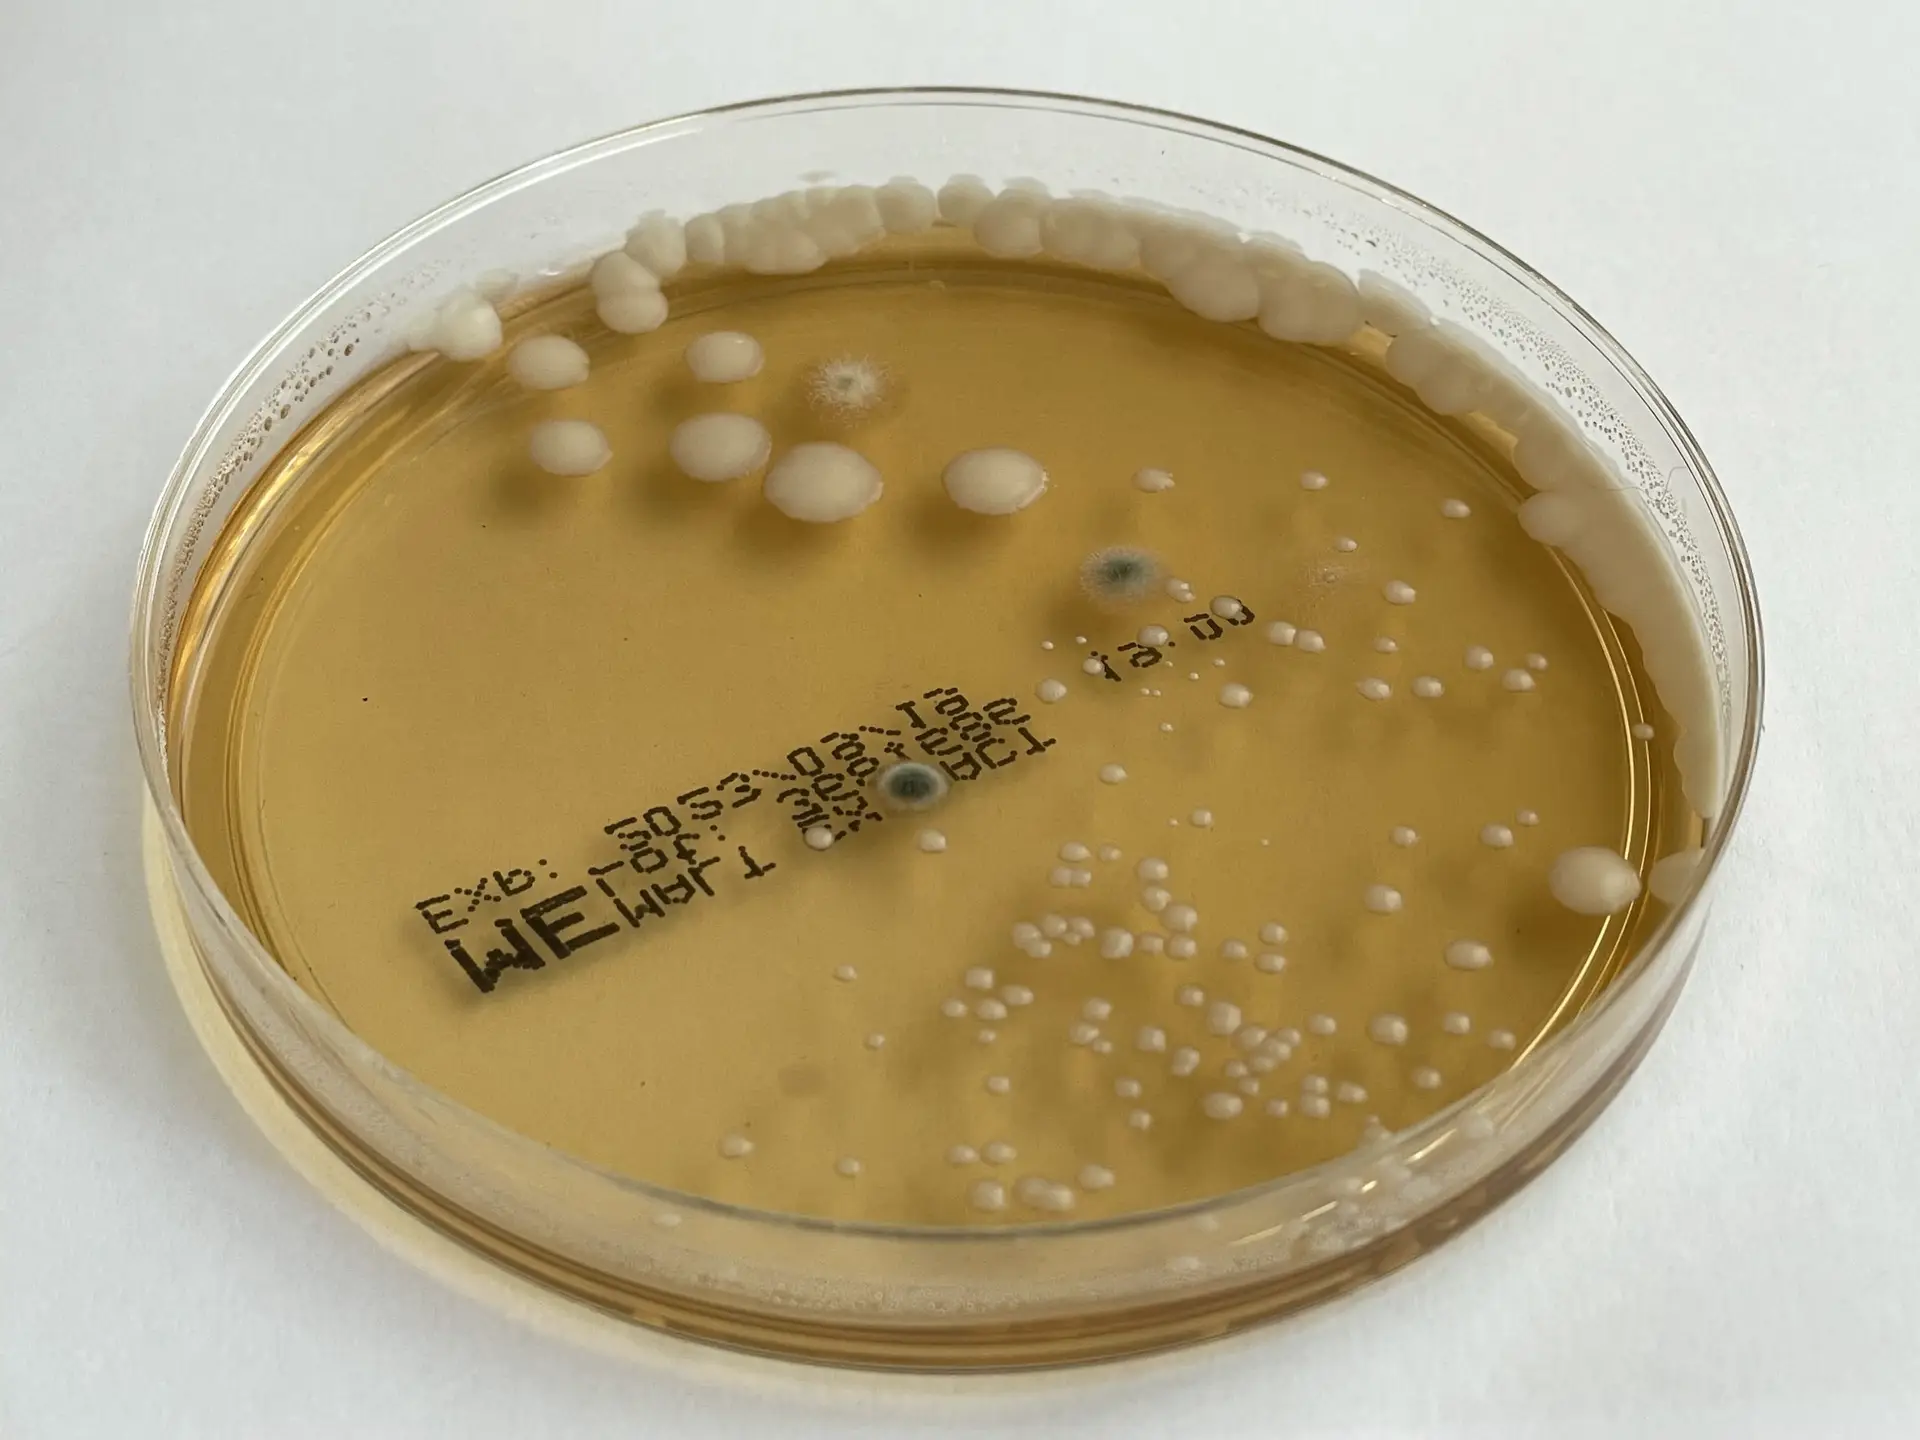
Mikrobiologische Analyse - Bakterienkolonien auf Nährboden

Hygieneinspektion nach VDI 6022
Die Hygieneinspektion ist die Grundlage für den hygienisch einwandfreien Betrieb Ihrer Lüftungsanlage. Wir prüfen, messen und dokumentieren – damit Sie auf der sicheren Seite sind.
Was ist eine Hygieneinspektion nach VDI 6022?
Eine Hygieneinspektion ist die systematische Überprüfung einer raumlufttechnischen Anlage (RLT-Anlage) auf hygienische Mängel. Die VDI 6022 unterscheidet zwischen der Hygieneerstinspektion – die den Ist-Zustand einer Anlage erfasst – und der regelmäßigen Hygienekontrolle, die den fortlaufenden Betrieb überwacht.
Die Raumlufttechnik (RLT) unterliegt strengen Hygieneanforderungen. Die Richtlinie VDI 6022 des Vereins Deutscher Ingenieure (VDI) definiert die Mindestanforderungen an die Hygiene in raumlufttechnischen Anlagen und ist in Deutschland als anerkannte Regel der Technik etabliert.
Die Inspektion umfasst eine visuelle Beurteilung aller Anlagenkomponenten, mikrobiologische Messungen der Luft und Oberflächen sowie eine Bewertung der Anlagendokumentation. Ziel ist es, gesundheitsgefährdende Zustände frühzeitig zu erkennen und Maßnahmen wie eine professionelle Lüftungsreinigung einzuleiten, bevor die Raumluftqualität beeinträchtigt wird.
Die VDI 6022 fordert eine Hygieneinspektion alle zwei Jahre für Anlagen mit Befeuchtung und alle drei Jahre für Anlagen ohne Befeuchtung. Als Betreiber sind Sie für die Einhaltung dieser Intervalle verantwortlich.
Was wir bei einer Hygieneinspektion prüfen
Unsere Inspektion folgt dem standardisierten Prüfschema der VDI 6022 und umfasst drei Hauptbereiche. Sollte die Inspektion Handlungsbedarf ergeben, können wir direkt eine fachgerechte Lüftungsreinigung anschließen.
Visuelle Inspektion
Sichtprüfung aller Anlagenkomponenten: Zustand der Kanäle, Filter, Wärmetauscher, Befeuchter, Schalldämpfer und Gehäuse. Suche nach Korrosion, Ablagerungen, Feuchteschäden und unzulässigen Materialien.
Luftkeimmessung
Messung der Keimbelastung der Zuluft und Raumluft mit kalibrierten Impaktionssammlern. Bestimmung der Gesamtkeimzahl (KBE/m³) und Vergleich mit den Grenzwerten der VDI 6022.
Abklatschproben
Oberflächenproben an kritischen Stellen der Anlage (Befeuchter, Kanalinnenflächen, Wärmetauscher). Laboranalyse auf Schimmelpilze, Bakterien und Hefen mit Artbestimmung bei Auffälligkeiten.
Anlagendokumentation
Prüfung der vorhandenen Betriebsdokumentation: Wartungsnachweise, Filterwechselprotokolle, Reinigungsnachweise. Bewertung, ob die geforderte Dokumentation vollständig vorliegt.
Klimamessungen
Messung von Temperatur, Luftfeuchtigkeit und Luftgeschwindigkeit an relevanten Stellen. Abgleich mit den Sollwerten und Bewertung der Behaglichkeitskriterien.
Maßnahmenplan
Bewertung aller Befunde nach Dringlichkeit (sofort, kurzfristig, mittelfristig). Konkrete Handlungsempfehlungen mit Priorisierung und Kostenschätzung für notwendige Maßnahmen.
Was Sie nach der Inspektion erhalten
Sie erhalten einen umfassenden Inspektionsbericht, der alle Prüfergebnisse zusammenfasst und als rechtssichere Dokumentation dient.
- Detaillierter Prüfbericht nach VDI 6022 mit Bewertung aller Anlagenkomponenten
- Fotodokumentation des Anlagenzustands mit Kommentierung
- Laborergebnisse der Luftkeim- und Oberflächenmessungen
- Bewertungsmatrix mit Ampelsystem (grün / gelb / rot) pro Komponente
- Priorisierter Maßnahmenplan mit Empfehlungen und Fristen
- Nachweis über die durchgeführte Inspektion für Behörden und Versicherungen
📌 Wichtig für Betreiber
Auf Basis des Inspektionsberichts empfehlen wir bei Bedarf weiterführende Maßnahmen wie die Lüftungsreinigung, eine Kanalabdichtung mit AeroSeal oder – bei Trinkwasserkomponenten – eine Trinkwasserhygiene-Prüfung. Der Inspektionsbericht ist Ihre Dokumentation gegenüber Gesundheitsämtern, Gewerbeaufsicht und Versicherungen. Bewahren Sie ihn sorgfältig auf – er belegt die Einhaltung Ihrer Betreiberpflichten.
Wann und wie oft sollten Sie inspizieren lassen?
Anlagen mit Befeuchtung
Alle 2 Jahre ist eine Hygieneinspektion Pflicht. Befeuchtungssysteme bieten ideale Bedingungen für mikrobielles Wachstum – regelmäßige Kontrolle ist hier besonders wichtig.
Anlagen ohne Befeuchtung
Alle 3 Jahre ist eine Hygieneinspektion vorgeschrieben. Auch ohne Befeuchter können sich Staub und Mikroorganismen in der Anlage ansammeln.
Sensible Bereiche
In Krankenhäusern, Laboren und Reinräumen gelten kürzere Intervalle. Hier empfehlen wir eine jährliche Inspektion – die genauen Anforderungen besprechen wir individuell.
Hygieneinspektion fällig?
Wir prüfen Ihre Lüftungsanlage nach VDI 6022 – zuverlässig, schnell und mit vollständiger Dokumentation.